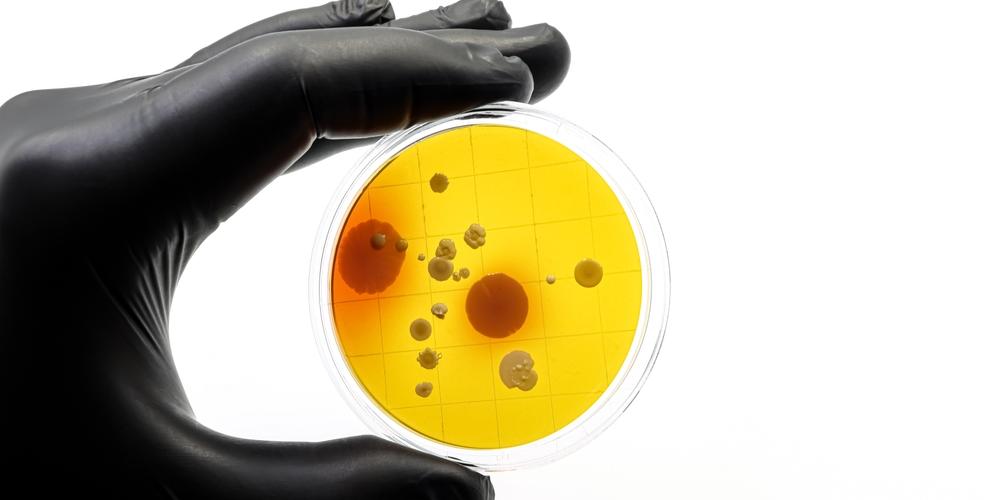
Onderzoek naar antibiotica

Antibiotica hebben de geneeskunde ingrijpend veranderd. Maar door jarenlang overmatig en verkeerd gebruik vertonen steeds meer bacteriën een resistentie voor die geneesmiddelen. “Antibioticaresistentie is een van de grootste gezondheidsproblemen van deze tijd”, zegt onderzoekster Yana Girardin van de onderzoeksgroep Structural Biology Brussels (Faculteit Wetenschappen en Bio-ingenieurswetenschappen, VUB) in haar doctoraat. “Je kan het gerust een stille pandemie noemen. Bacteriën worden steeds ongevoeliger voor bestaande medicijnen, waardoor eenvoudig te behandelen infecties opnieuw levensbedreigend kunnen worden.” De zoektocht naar alternatieve oplossingen is volgens haar dan ook cruciaal.
Een veelbelovend spoor ligt in de zogeheten toxine-antitoxine (TA)-systemen, ingebouwde mechanismen in bacteriën die bestaan uit twee onderdelen. Enerzijds een toxine dat de groei van de bacterie kan stilleggen of haar zelfs kan doden, anderzijds een antitoxine dat het effect ervan neutraliseert. Het doctoraat van Yana focuste op zo’n systeem bij Vibrio cholerae, de bacterie die cholera veroorzaakt.
Centraal in haar onderzoek stonden twee eiwitten: het toxine VcParE2 en het antitoxine VcParD2. Het toxine schakelt een cruciaal enzym van bacteriën uit, het gyrase-enzym, dat gekend is als doelwit van bepaalde antibiotica. “Wat bijzonder is”, legt Girardin uit, “is dat VcParE2 dat op een andere manier doet dan de antibiotica die we vandaag kennen. Dat opent de deur naar een heel nieuw werkingsmechanisme.”
Om het toxine en zijn antitoxine in detail te kunnen bestuderen, moest Girardin eerst een praktische hindernis overwinnen: het toxine is zo krachtig dat het de bacteriën die het aanmaken doodt, wat het bijzonder moeilijk maakt om dit toxine in het labo te produceren. De zoektocht naar een geschikte manier om VcParE2 aan te maken leverde waardevolle methoden voor het werken met toxische bacteriële eiwitten. Zo bedacht Yana een slim controlesysteem waarmee het toxine-gen in bacteriën kan worden gebracht, zonder dat die meteen sterven. Die aanpak maakt het bovendien mogelijk om de toxiciteit van verschillende toxines met elkaar te vergelijken. Daarnaast slaagde ze erin om dankzij alternatieve productiemethoden, zoals het gebruik van insectencellen, voldoende hoeveelheden van het eiwit aan te maken. “Dat was echt een doorbraak,” zegt ze, “want het zuiveren van het toxine op zichzelf was tot nu toe nog nooit gelukt door de extreme toxiciteit ervan.”
Uit haar experimenten bleek welke specifieke regio van het toxine verantwoordelijk is voor de remming van het gyrase-enzym, en hoe het antitoxine precies die plek afschermt om schade te voorkomen. Daarmee bracht ze niet alleen dit specifieke systeem in Vibrio cholerae in kaart, maar droeg ze ook bij aan een breder inzicht in hoe TA-systemen werken.
“Ons onderzoek toont hoe bacteriën hun eigen groei kunnen afremmen en hoe we dat mechanisme beter kunnen begrijpen”, besluit Girardin, “en die kennis kan waardevol zijn bij de zoektocht naar nieuwe strategieën tegen antibioticaresistentie.”
Meer info: Yana Girardin: yana.andrea.girardin@vub.be Exploring the interaction landscape of Vibrio cholerae toxin ParE2: Gyrase inhibition and neutralization by ParD2